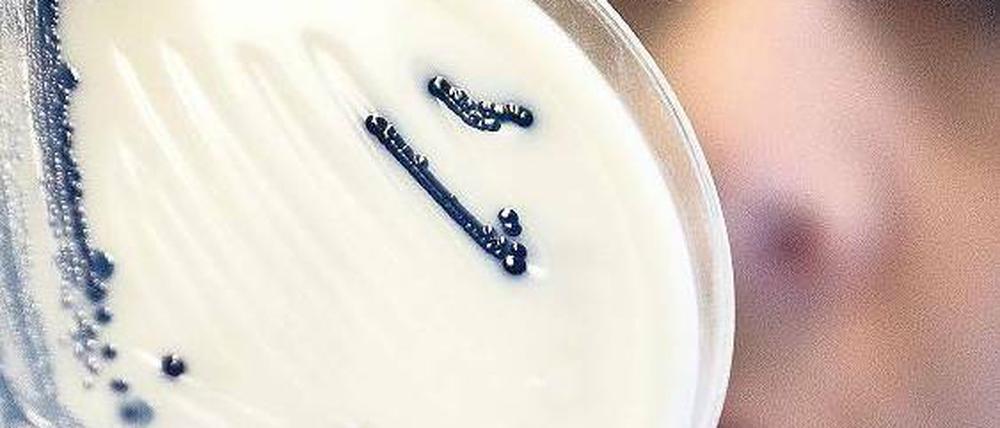
Gefährlicher Keim. 3842 Menschen erkrankten in diesem Sommer in Deutschland an einer Ehec-Infektion, 53 starben an den Folgen, heißt es im Abschlussbericht des RKI. Foto: dapd

© dapd
Wissen: Erreger mit Tarnkappe
Ehec und die Folgen: Das Krisenmanagement soll sich verbessern, das Bakterium mehr erforscht werden
Stand:
Er solle sich darauf einstellen, dass es diesmal noch viel stressiger werden könne als bei der „Schweinegrippe“. Das schärften dem frisch gebackenen Gesundheitsminister Daniel Bahr seine Mitarbeiter ein, als er am 19. Mai, eine Woche nach seinem Amtsantritt, mit dem Ehec-Ausbruch konfrontiert war.
Tatsächlich stellte der bisher größte Ausbruch von Erkrankungen nach einer Infektion mit dem enterohämorrhagischen Escherichia-coli-Bakterium O104 in Deutschland eine Ausnahmesituation dar. Weltweit war er ohne Beispiel, was die Anzahl der Erkrankungen am gefährlichen hämolytisch-urämischen Syndrom (Hus) betrifft. Die Zahlen aus dem gerade erschienenen Abschlussbericht des Robert-Koch-Instituts (RKI) über den Ausbruch im Frühsommer 2011: Insgesamt rechnet das RKI 3842 Erkrankungen dem Ausbruch zu, davon 855 mit Hus. 53 Menschen starben an der Erkrankung.
Jetzt, gut sechs Wochen nachdem das RKI den Ehec-Ausbruch offiziell für beendet erklärt hat und passend zum Erscheinen des Abschlussberichts, zeigte sich der Minister in einer Podiumsdiskussion bei der Jahrestagung der Deutschen Gesellschaft für Nephrologie sehr zufrieden: „Besonders gut gelungen ist die Kooperation der Kliniken über Ländergrenzen hinweg.“ Hier komme den Nierenspezialisten, die sich um die Hus-Patienten kümmerten, ein besonderes Verdienst zu.
Schon am Vortag war auf dem Kongress, der bis Dienstag läuft, das Tempo gelobt worden, mit dem die Sprossen als „schuldiges“ Lebensmittel ausfindig gemacht waren. Für den Laien mag das überraschend sein, erlebte die Öffentlichkeit die Suche doch zunächst als eine Reihe von Misserfolgen. Aber Gérard Krause, Leiter der Abteilung für Infektionsepidemiologie beim RKI, zog einen Fall aus den USA zum Vergleich heran: Als dort im Jahr 2008 ein Ausbruch des Salmonellenstamms Saintpaul die Bevölkerung beunruhigte, dauerte die Suche sieben Wochen. An Durchfall waren Menschen erkrankt, die verseuchte Chilischoten gegessen hatten. Den wenigsten war das allerdings bewusst, denn das scharfe Gemüse bereicherte kleingeschnitten handelsübliche Tomatensaucen. Bis Sprossen, die aus Samen von ägyptischem Bockshornklee gezogen worden waren, als Quelle des O104:H4 identifiziert wurden, dauerte es nur drei Wochen.
Dabei sind auch die Sprossen in den Augen der Experten „Tarnkappen-Lebensmittel“, an die die wenigsten Erkrankten denken, wenn sie den Speiseplan der vergangenen Tage durchgehen. Dass Ehec aus der „Beigabe“ Sprossen stammte, ergab erst eine Befragung der Köche in der rezeptbasierten Restaurant-Kohorten- Studie, in deren Rahmen den erkrankten Gästen Fotos der Gerichte gezeigt werden konnten. In allen 41 Lokalen und Kantinen, die mehrere Erkrankte besucht hatten, waren Sprossen eines Betriebs aus Niedersachsen serviert worden, wie das Robert-Koch-Institut nun in seinem Abschlussbericht feststellt.
„Die Identifikation der Sprossen ist im weltweiten Maßstab eine Spitzenleistung“, lobte Bahr. RKI-Präsident Reinhard Burger hob zudem die Leistung der Mikrobiologen um Helge Karch von der Uni Münster hervor, die mit dem Nationalen Referenzzentrum für Salmonellen und andere bakterielle Enteritiserreger in Werningerode schon kurz nach Bekanntwerden des Ausbruchs ein Nachweisverfahren für den Erreger vorlegen konnten. Die schnellen Fahndungserfolge in Sachen Infektionsquelle und Erreger erkannte bei der Podiumsdiskussion auch der SPD-Gesundheitsexperte Karl Lauterbach an. Zum allgemeinen Anerkennungscocktail steuerte der Oppositionspolitiker allerdings gezielt einen Wermutstropfen bei: „Die gute Aufklärung ist trotz des nicht so guten Meldewesens gelungen.“
Lauterbach wünscht sich für die Kliniken die Möglichkeit, Fälle direkt an das RKI zu melden, statt den Dienstweg über die Gesundheitsämter und Länderbehörden zu nehmen. „Wie kann man zufrieden sein, wenn es zehn Tage dauert, bis eine Meldung beim RKI ankommt“, fragte auch Reinhard Brunkhorst, Präsident der Deutschen Gesellschaft für Nephrologie. Bei der Fahndung nach der Infektionsquelle sollten die behandelnden Ärzte stärker einbezogen werden.
Als Manko im Ehec-Management sprach Tagungspräsident Ulrich Frei, Ärztlicher Direktor der Charité, die während des Ausbruchs schwer kranke Patienten aus Norddeutschland „übernommen“ hatte, die Kommunikation an. Die Mitstreiter auf dem Podium pflichteten ihm bei. Zwar meinte der Minister, im Vergleich zur allgemeinen Aufregung über „zu wenig“ oder „zu viel“ Impfstoff gegen die „Schweinegrippe“ H1N1 sei es so schlecht gar nicht gelaufen. Doch auch er hätte sich die Kommunikation „ruhiger und mit mehr Rücksprache“ gewünscht. Die Kritik zielte auf Talkshowgäste. Es hätte Sendungen gegeben, in denen „sechs verschiedene Theorien zur Ursache von Ehec“ aufkamen, „von Bioterrorismus über Spargel und Erdbeeren bis zu den Schnittblumen vom Muttertag“. Lauterbach sagte, einige Landesminister hätte sich mehr zurücknehmen sollen.
Aus wissenschaftlicher Sicht sind noch viele Fragen offen. Wie es den schwer erkrankten Hus-Patienten weiter ergehen wird, die bundesweit in 67 nephrologischen Zentren behandelt wurden, dokumentiert ein Register der Fachgesellschaft. Und auch über das Bakterium Ehec O104 selbst wird weiter geforscht: „Wir wissen noch wenig darüber, wie der Stamm entstanden ist und wie er sich weiterentwickeln wird“, sagte Mikrobiologe Karch. Ehec O104 ist neu in der beträchtlichen Sammlung von HUS erzeugenden E.-coli-Bakterien, die er und seine Münsteraner Kollegen seit Jahren führen. „Dieser Stamm war nirgendwo auf der Welt bekannt, ihn hatte niemand im Visier.“
- showPaywall:
 - false
 - isSubscriber:
 - false
 - isPaid: